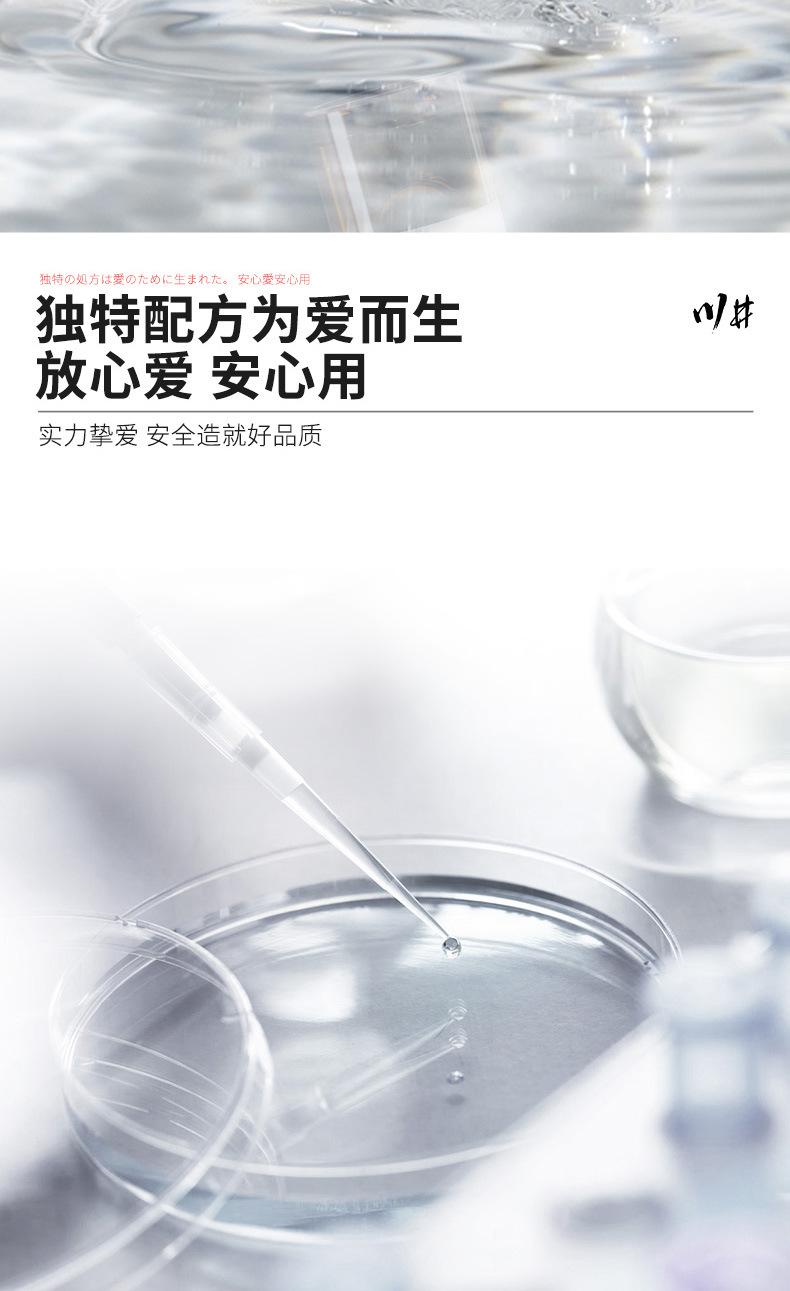
undefined

Search history
Clear allSearch by image
XDrag and drop an image here or upload an image
Max 5MB per image
UploadSign In | Join
X Email Mobile
kawai tokyo pharmaceutical pleasure liquid
|
¥15.6 | 99967 bottle available |
|
A new item has been added to your Shopping Cart. You now have items in your Shopping Cart.

Update time:
TOP